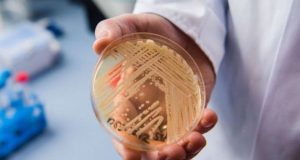

Ανησυχητικές διαστάσεις παίρνει η «ευλογιά των πιθήκων» καθώς μετά τη Βρετανία, κρούσματα εντοπίστηκαν και στην Πορτογαλία αλλά και στην Ισπανία. Σύμφωνα με τις τελευταίες πληροφορίες, έξι άνθρωποι βρέθηκαν θετικοί στην Πορτογαλία...


Το μέλλον της Covid-19 μπορεί να είναι ένας ιός που δεν λέει να εξαφανιστεί, ο οποίος «γεννά» αφενός νέες παραλλαγές ικανές να διαφεύγουν εν μέρει από τις άμυνες...


Η υπέρταση είναι μια μακροχρόνια κατάσταση όπου η αρτηριακή πίεση αυξάνεται. Επηρεάζει περισσότερους από 1,4 δισεκατομμύρια ανθρώπους και είναι η κύρια αιτία πρώιμων θανάτων παγκοσμίως, υπεύθυνη...


Το τεστ ELISA παρέχει έτσι μια νέα μη επεμβατική μέθοδο που μπορεί να χρησιμοποιηθεί για να διαπιστωθεί ο βαθμός στον οποίο ένας πληθυσμός έχει εκτεθεί στην Covid-19,...


Δύο ακόμη άτομα διαγνώστηκαν με την «ευλογιά των πιθήκων» στο Λονδίνο, επιβεβαίωσε ο Οργανισμός Υγειονομικής Ασφάλειας του Ηνωμένου Βασιλείου (UKHSA). Το ζευγάρι ζει στο ίδιο σπίτικαι...


“Ψυχραιμία” συστήνει στους γονείς ο πρόεδρος της Ελληνικής Παιδιατρικής Εταιρείας, Καθηγητής, Ανδρέας Κωνσταντόπουλος, μετά την ανακοίνωση του ΕΟΔΥ για την εμφάνιση στην Αθήνα “ύποπτων” περιστατικών οξείας ηπατίτιδας σε...


Θέμα: ΕΠΙΔΗΜΙΟΛΟΓΙΚΗ ΕΚΘΕΣΗ ΟΞΕΙΑΣ ΗΠΑΤΙΤΙΔΑΣ ΑΓΝΩΣΤΟΥ ΑΙΤΙΟΛΟΓΙΑΣ Επιδημιολογία οξείας ηπατίτιδας ανά την υφήλιο Στις αρχές Απριλίου, παρατηρήθηκε στο Ηνωμένο Βασίλειο, ένας ασυνήθιστα υψηλός αριθμός περιπτώσεων οξείας...

Τι είναι ο μύκητας Candida Auris, που τον συνανταμε και πόσο πρέπει να ανησυχούμε; Απαντήσεις δίνει η Αριστέα Βελεγράκη καθηγήτρια Ιατρικής Σχολής ΕΚΠΑ, συστήνοντας ψυχραιμία και τήρηση...


Σύμφωνα με μελέτη ομάδα ερευνητών από το Ισραήλ, η προηγούμενη παραλλαγή του κοροναϊού εξακολουθεί να κυκλοφορεί “κρυφά”, ενώ δεν αποκλείεται να φέρει νέο “κύμα Δέλτα”, ή...


Ο ιός της εποχικής γρίπης Η1Ν1 πιθανότατα αποτελεί άμεσο “απόγονο” του στελέχους της ισπανικής γρίπης που το 1918-19, σύμφωνα με νέες εκτιμήσεις Ευρωπαίων επιστημόνων. Η μελέτη βασίζεται στη...


Δεν υπάρχει νοσοκομείο σε παγκόσμια κλίμακα που να μην έχει αυτό τον μύκητα, λέει ο καθηγητής Για τον μύκητα Candida Auris που φέρεται να έχει προκαλέσει επικίνδυνες λοιμώξεις...


Όλες οι αλλαγές. Αλλάζει ριζικά το φαρμακευτικό τοπίο για ασθενείς και φαρμακευτικές εταιρείες με τροπολογία που κατέθεσε σήμερα ο υπουργός Υγείας Θάνος Πλεύρης στο νομοσχέδιο για την Πρωτοβάθμια. Άμεσος...


Ο Παγκόσμιος Οργανισμός Υγείας ανακοίνωσε την περασμένη εβδομάδα ότι έχει λάβει αναφορές από 20 χώρες για τουλάχιστον 228 πιθανές περιπτώσεις παιδικής ηπατίτιδας Η Ινδονησία έχει ταυτοποιήσει...


Δύο νέες υποπαραλλαγές της Όμικρον, οι ΒΑ.4 και ΒΑ.5, που εμφανίστηκαν στη Νότια Αφρική και έχουν αρχίσει να εξαπλώνονται στην Ευρώπη και σε άλλες χώρες, δημιουργούν προβληματισμό...